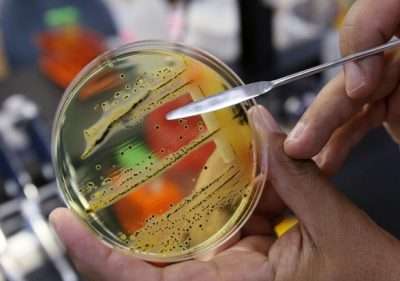

Головне управління Держпродспоживслужби в Тернопільській області поширило повідомлення RASFF про виявлення виявлення Salmonella у курятині механічного обвалювання, що експортувалась з Польщі
«Виявлення Salmonella (present/25g) у курятині механічного обвалювання, що експортувалась з Польщі (виробник: WCF Corp. Sp. z o.o., Warszawa) до України (отримувачі: ТОВ “М’ясний торговий дім”, вул. Академіка Каблукова, 21, оф. 1-2, м. Київ, 03065 — 13761 кг; ТОВ “Ред Міт”, Південне Шоссе, 57, оф. 44, м. Запоріжжя, 69032 — 517 кг)», – йдеться в повідомленні.
При виявленні даного продукту в обігу, громадян просять терміново повідомити Головне управління Держпродспоживслужби в Тернопільській області (м. Тернопіль, вул. Микулинецька, 20, тел. (0352) 52-10-10).
Сальмонельоз – це кишкове інфекційне захворювання, збудником якого є патогенні мікроорганізми і відносяться до роду Salmonella. Сальмонели можуть потрапити в продукти не тільки безпосередньо від тварин, але і під час транспортування, фасування, продажу та процесу приготування. Бактерії надзвичайно стійкі в зовнішньому середовищі, часом інфекція може передаватися через воду. Стійкість: кімнатний пил (до 90 днів); відкриті водойми (від 10 до 125 діб); ковбаси, м’ясо, молоко (2-6 місяців, в замороженому вигляді — до року); яйця (10-12 місяців); на шкаралупі до 1 місяця; вершкове масло (до 4 місяців).
Дія високих температур: при 56 0С гине через одну-півтори години, а ось при 71 0С вона загине за 61 секунду, при кип’ятінні — гине миттєво. Усередині м’яса сальмонела проявляє підвищену стійкість, гине через 10 хвилин при температурі 75 0С.